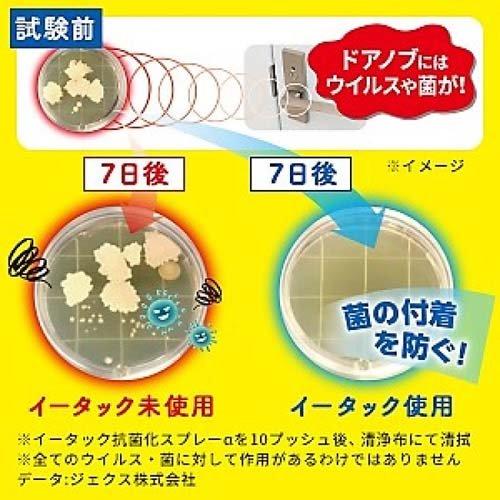
イータック抗菌化スプレーαつめかえ用 ( 200ml*6袋セット

イータック 抗菌化スプレーα 詰め替え用 イータック抗菌化スプレーα つめかえ用 200mL | エーザイの通信販売
(4019件)
Pontaパス特典
サンキュー配送
6750円(税込)
68ポイント(1%)
Pontaパス会員ならさらに+1%ポイント還元!
送料
(
)
4006
配送情報
お届け予定日:2026.05.30 8:20までにお届け
※一部地域・離島につきましては、表示のお届け予定日期間内にお届けできない場合があります。
ロットナンバー
85603175629
お買い物の前にチェック!

Pontaパス会員なら
ポイント+1%
ポイント+1%
商品説明

- 製品名: イータック抗菌化スプレーα詰替え用- 内容量: 200ml☓2袋- 用途: ウイルス・菌の除去- 持続効果: 1週間持続- 成分: ノンアルコール- 製造会社: エーザイ株式会社20袋のセット新品・未開封品となりますがあくまで素人保管になります。完品をお求めの方はご購入ご遠慮ください。本商品のみでのお値引きはご遠慮ください。他の商品を含めまとめての購入であればお値引きご対応いたします♪ぜひご活用ください同商品複数個在庫があることもございます。必要個数をお申し付けいただければお値引き対応いたします。購入の前にプロフィール欄を一読いただいてからご購入をお願い致します。あくまで素人の梱包ですので過度な期待はしないようにお願いします。簡易包装での発送となります。
| カテゴリー: | ダイエット・健康>>>衛生日用品>>>除菌剤・抗菌剤 |
|---|---|
| 商品の状態: | 新品、未使用","新品で購入し、一度も使用していない |
| ブランド: | Eisai |
| 配送料の負担: | 送料込み(出品者負担) |
| 配送の方法: | 佐川急便/日本郵便 |
| 発送元の地域: | 茨城県 |
| 発送までの日数: | 2~3日で発送 |
レビュー
商品の評価:




 4.3点(4019件)
4.3点(4019件)
- kasumi1495
- すぐに届きました。ありがとうございました!
- ちぃめみ
- 少し前に購入し、生理が来たので使用してみました。 現在2日目ですが、1日目の最初の時では、まだ血の量も少なかったこともあり、挿入時に少し痛かったです… また、奥まで入れれなかったため、不快感もありましたが、 その後何度か挑戦しているうちにこのあたりというのがわかってきました。 最初は怖かったのでこちらのセットを購入しましたが、骨盤底筋で下げるとリングが触れるので、糸はなくてもいいかな?と思っています。 ただ、まだ少し怖く、トイレのたびに膣の中で場所がかわらずしっかりあるか把握できるので助かっています。 子供を2人出産、生理は2日目でもタンポンは3〜4時間でナプキンにつくような感じで、メールで相談してLサイズを購入 出血量を考えるとサイズは良かったと思いますが、やはり大きいので挿入時と出す時にドキドキします… SMサイズはみていないけど、やはり経産婦さんじゃないと怖いのかな?と思います… 自分自身がビビリで、タンポンなども最初は奥まで入れることができなかったので、慣れだとは思いますが… 挿入時パンチダウンフォールドのように潰して入れ、ある程度のところでカップが開いたか確認してからさらに奥に入れています。 2回目はお風呂場で交換 カップの中に結構溜まっていて、その間は漏れることはありませんでしたが、、カップを外してから次につけるまでに垂れてきた血に関してはナプキンに垂れるので、何もつけないというわけにはいかないです。 お風呂の方が楽に挿入できると思いましたが、体が濡れていたからか、体制が違うからか、その後にトイレで入れ直した方がすんなりできました笑 あとはもう少しコツが掴めるようになると嬉しいなぁと思います。
- 太郎ママ2959
- ここ数年、子宮筋腫による月経過多に悩まされていました。多い時はタンポン+ナプキンで1時間も保たず、塊もたくさん出ます。婦人科に行ってもホルモン療法で月経を止めると言われ、体に負担はかけたくないし・・・と思っていた時に「月経カップ」に出会いました。 色々とレビューを参考に、とにかく一番容量の多いスーパージェニーを購入しました。結論から言うと「すごい!!!」の一言です。生理に対する考え方が180度変わりました。今まで悩んでいた どろっと経血、ナプキンかぶれ、蒸れ、すべてが一気に解消されました。ただ、使い始めていくと色々な疑問が湧きましたが、とりあえず他の方のレビューを参考に自分なりに使いこなして、やっと初めての1クールが終わりました。 一番気になったのが、カップを装着してから時々聞こえる空気音と経血が流れ出る感じです。子宮あたりから「ゴボゴボ」と空気が動く音と同時に、経血が流れ出ている感じが時々ありました。『あっ、漏れてるっ!』と思いナプキンを確認すると漏れてない・・・月経カップを装着しているのに、膣の中で経血が流れるのを感じるのは量が多いからなのでしょうか?!装着が浅かったのかと思い少し奥に入れ直してみましたが同じような現象がその後もありました。他の方のレビューに『カップがいっぱいになるとポコポコと空気が動く』とありましたが、カップが満タンではなかったし。。。自分なりの使い方やコツをマスターするには数回、生理周期をこなす必要がありそうですね。今まで本当に生理が苦痛でしかありませんでしたが、月経カップを使い始めてからは次の生理が楽しみになりました!『次回は前回よりも使いこなせるようになりたい!』と前向きになれますよ。 私のように月経過多に悩んでいる方には、本当に本当にオススメです!もっと月経カップが身近な生理用品になるように、婦人科などでも紹介してくれればいいのにと思いました。私自身も、もっと早くに月経カップに出会いたかったです!
- みら4546
- 2回目の生理期間を終えたのでレビューします。身長156センチ経産婦です。カップは2つ目。前回は別メーカーのものが大きすぎて合わず、こちらのMサイズボールを購入。初回は漏れたりボールが飛び出たりしてうまく装着できず、快適さも実感できず。今回はハーフダイヤモンドという折り方で試しました。試行錯誤の末歩いてもボールが擦れて痛いということもなく、ようやく快適さを実感!もっともっとはやく出会いたかった!
- さやぴ331626
- 初日は緊張してなかなか入らず。2日めは逆に奥まで入りすぎて取り出すのに時間がかかり焦った。 3日め以降も奥に入りすぎる恐怖が少しあり、慣れるまでにはもう少し時間がかかりそうだがら便利だということは認識している。
- ちゃお4280
- 配送がとても早くて良かったです! ずっと買おうか悩んでましたけどみなさんのレビューを見て決心! 使うのが楽しみです。 説明書も使い方やお手入れの仕方などわかりやすく書かれていて良かったです。 まだ使用していないのでまた使用後にレビュー書きます!
- ぷーこ1022
- 自分の本当の経血量を知れるのもいいですね。ナプキンだとすごい出てるように見えたけどそんなこともないんだなーと面白く思いました。夜の漏れがなくなって嬉しいですし、かぶれからも解放されました。外出時は洗い替えに手間取るかもしれませんが、自粛の今にぴったりなアイテムです!
- pekiko0906
- ずっとタンポンを使っていたのですが日ごろから紐が気になることが多く、最近よく見る月経カップを試してみようと思って購入しました。 身長166センチ、出産経験なしで血液量は少なめなのでSサイズにしました。 届いたのがちょうど生理3日目でしたのでその日から使いはじめましたが、快適です!最初に入れるときはちょっとコツがいるなと思いましたが、入ってからはタンポンより違和感なく利用することができました。出すときが少し不安でしたが、腰を前に突き出すようにしてお腹に力を入れるとカップが下がってくることが分かったので、あとはリングをつまんで引き出すだけと簡単でした。コットン糸も初回しか使いませんでした。 生理期間ずっと使っていたわけではありませんが、家にいる間ならタンポンより楽だと感じたので続けてみたいと思います。
- nyanko.nyanko3
- 164cm普通体型、1人目経膣2人目帝王切開で出産しています。挿入はコツを掴みましたが、取り出しがまだ模索中です。うまく折り曲げて出さないと縁が引っかかって痛い。でも折り曲げると満タンに溜まった経血が溢れて手が血塗れになる。 溜まり過ぎる前に折り曲げて取り出してみても、やっぱり痛くて…。挿入中の快適さは最高なので、次はソフトを購入してみます。
すべて見る
お店の情報
7,367
連絡・応対
4.3
配送スピード
4.3
梱包
4.3